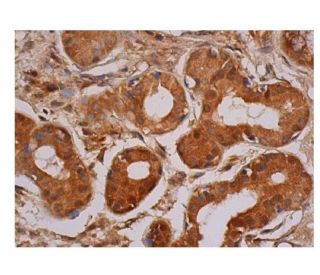
SREBP-1 Antibody (A-4) | SCBT - Santa Cruz Biotechnology

マイストア
変更
お店で受け取る
(送料無料)
配送する
納期目安:
2025.12.09 8:8頃のお届け予定です。
決済方法が、クレジット、代金引換の場合に限ります。その他の決済方法の場合はこちらをご確認ください。
※土・日・祝日の注文の場合や在庫状況によって、商品のお届けにお時間をいただく場合がございます。
N様 SREBP-1 (A-4) Antibody sc-365513 from Santa Cruz Biotechnologyの詳細情報
SREBP-1 (A-4) Antibody sc-365513 from Santa Cruz Biotechnology。srebp-1-antibody-a-4-。SREBP-1 Antibody (A-4) | SCBT - Santa Cruz Biotechnology。別注 MULTI PATERN S/S SHIRT(36 GREY): N.HOOLYWOOD: MENS|THE TOKYO。30パック
ベストセラーランキングです
近くの売り場の商品
カスタマーレビュー
オススメ度 4.7点
現在、3497件のレビューが投稿されています。